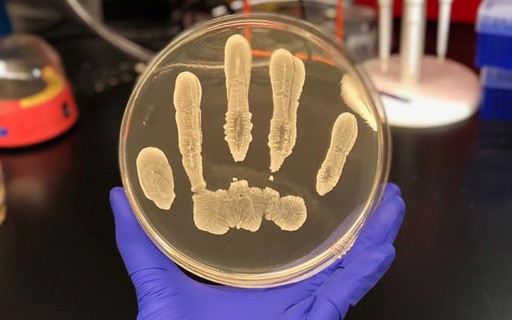

Informações completas sobre Exemplo De Bactérias úteis Que Vivem Em Nosso Corpo.
Do Intestino Ao Cerebro Os Micro Organismos Tem Um Papel

Fonte de : www.gazetadopovo.com.br
Dr Danilo Biegas Posts Facebook

Fonte de : www.facebook.com
Armas Germes E Aco Jared Diamond Pdf Eljq1jqyov41

Fonte de : idoc.pub
Revista Recreio Yu Gi Oh Saiba Tudo Sobre O Desenho F269 R 25

Fonte de : produto.mercadolivre.com.br
Sao Invisiveis Estao Por Toda A Parte E Mandam Em Nos

Fonte de : nationalgeographic.sapo.pt
2

Fonte de :
Probioticos Ajudam A Combater 9 Problemas Serios De Saude Veja Saude

Fonte de : saude.abril.com.br

Aqui está a informação completa sobre exemplo de bactérias úteis que vivem em nosso corpo. O administrador do blog de Novo Exemplo 01 January 2019 também coleta outras imagens relacionadas ao exemplo de bactérias úteis que vivem em nosso corpo abaixo.
Importancia Das Bacterias Para O Homem Bacterias Alunos Online

Fonte de : alunosonline.uol.com.br
Calameo Pdf Downloader

Fonte de : calameo.pdf-downloader.com
Habitos Saudaveis Mudancas Na Rotina Para Ganhar Saude

Fonte de : www.davita.com.br
Bacteria Comum Que Vive Em Nossa Pele Pode Ser Protecao Contra

Fonte de : revistagalileu.globo.com
10 Bacterias Uteis Ao Ser Humano Explique A Caracteristica E A

Fonte de : brainly.com.br
Bacterias Do Bem 5 Passos Para Cuidar Bem Dos Microorganismos Que

Fonte de : www.semprefamilia.com.br
Virus Vida E Obra Do Mais Intrigante Dos Seres Super

Fonte de : super.abril.com.br
Filosofia Oriental Posts Facebook

Fonte de : www.facebook.com
2

Fonte de :
Essa é a discussão que podemos fornecer sobre exemplo de bactérias úteis que vivem em nosso corpo. Obrigado por visitar o blog Novo Exemplo 01 January 2019.